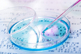
GettyImages-477335408-dna

ABOUT AGC BIOLOGICS
AGC Biologics is a leading global biopharmaceutical Contract Development and Manufacturing Organization (CDMO) committed to delivering the highest standard of service and collaboration to our clients and partners as we work side-by-side to help bring their products to patients across the globe. We offer world-class development and manufacturing services of mammalian and microbial-based therapeutic proteins, plasmid DNA (pDNA), messenger RNA (mRNA) viral vectors, and genetically engineered cells. Our global network of seven facilities spans three continents, allowing us to develop and manufacture products in locations that fit our clients' geographic needs. We have cGMP-compliant facilities in Seattle, Washington; Boulder and Longmont, Colorado; Copenhagen, Denmark; Heidelberg, Germany; Milan, Italy; and Chiba, Japan.
We forge exceptionally strong partnerships with our customers and we never lose sight of our commitment to deliver reliable and compliant drug substances. AGC Biologics has a proven track record of more than 200 projects completed across 110+ customers, from pre-clinical studies through commercial production.
Our vision is to be the first provider that customers call when they are looking for a Contract Development Manufacturing Organization.
FEATURED WEBINARS
-
Review the critical parameters for scalable production during upstream and downstream process development, with details on achieving scalable transfection in adherent and suspension platforms.
-
Explore the key advantages of a proven approach to scale the lentiviral vector (LVV) production process (48L cf) in a bioreactor (200 L) without changing critical quality attributes (CQAs).
CONTACT INFORMATION
AGC Biologics
21511 23rd Dr. SE
Bothell, WA 98021
UNITED STATES
Phone: (425) 419-3555
Contact: Nick McDonald